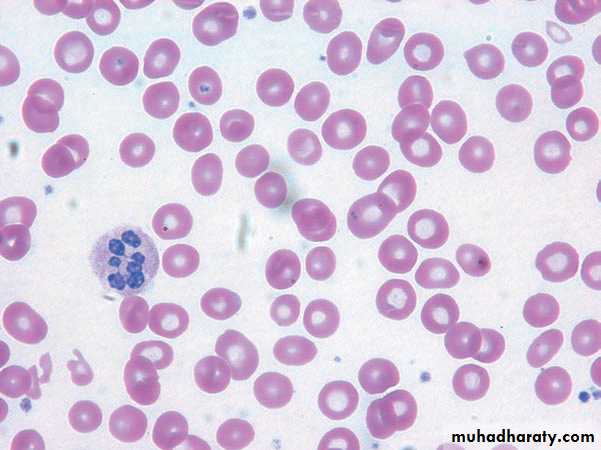

MALABSORPTIONTUCOMInternal Medicine4 th year 20-10-2016Dr. Hasan I. Sultan
Malabsorption: learning objectives• Outline the function of small intestine.
• Define malabsorption.
• Identify the causes and pathogenesis of malabsorption.
• Explain the clinical manifestations of malabsorption.
• review the investigations of malabsorption.
• Recognize the definition, causes, C F, investigations, management and complications of celiac disease.
• List the causes of subtotal villous atrophy.
• Define the following; Dermatitis herpetiformis ,Tropical sprue, small bowel bacterial overgrowth and ileal resection malabsorption.
Small intestine:
The small intestine extends from the ligament of Treitz to the ileocaecal valve. The average length of the small intestine in an adult is about 7 m. Which divided into three parts: duodenum, jejunum and ileum.Functions of the small intestine are:
• Digestion: (mechanical, enzymatic and peristaltic)
• Absorption: the products of digestion, water, electrolytes and vitamins
• Protection: against ingested toxins
• Immune regulation
1-Digestion and absorption of fat
2-Digestion and absorption of carbohydrates;Composed of;
A- Polysaccharide starch – amylases action-- alpha-limit dextrins – maltose and maltotriose.
B- Disaccharides (sucrose and lactose) are hydrolyzed by brush border sucrase and lactase enzymes to momosaccharides.
C- Monosaccharides glucose, galactose are actively transport and fructose by simple diffusion.
3- Digestion and absorption of proteins
MALABSORPTION
Define; as a clinical syndrome due to diminished intestinal absorption of one or more dietary nutrients. Includes a broad spectrum of conditions with multiple aetiologies and varied clinical manifestation.Aetiology and pathogenesis; due to abnormalities of the three processes of normal digestion.
1-Intraluminal maldigestion
a-Reduced nutrient availabilityCofactor deficiency (pernicious anemia, gastric surgery)Nutrient consumption (bacterial overgrowth)
b-Impaired fat solubilizationReduced bile salt synthesis (hepatocellular disease)Impaired bile salt secretion (chronic cholestasis)Increased bile salt losses (terminal ileal disease)
c-Defective nutrient hydrolysisLipase inactivation (ZE syndrome)Enzyme deficiency (pancreatic insufficiency or cancer)Improper mixing or rapid transit (resection, bypass, hyperthyroidism)
2-Mucosal malabsorption
a-Extensive mucosal loss (resection or infarction)b-Diffuse mucosal disease (celiac disease,Crohn's disease, irradiation, infection, infiltrations)
c-Brush border hydrolase deficiency (lactase deficiency)
d-Epithelial processing (abetalipoproteinemia)
3-Postmucosal malabsorption
a-Vascular conditions (vasculitis, atheroma)
b-Lymphatic conditions (lymphangiectasia, irradiation, nodal tumor, cavitation, or infiltrations)
4- Multiple Mechanisms:
Example: Subtotal gastrectomy leads to premature gastric emptying resulting in impaired mixing of food with bile and pancreatic enzymes, associated with bacterial overgrowth due to hypochlorhydria.Clinical features of malabsorption
Early features; usually diarrhea and weight loss.Late features; symptoms and signs of nutrient deficiencies.
1- Gastrointestinal features;
a-Steatorrheic stool; Mucosal disease, bacterial overgrowth, or pancreatic insufficiency.
b-Distention; Intestinal obstruction, gas, ascites, pseudocyst (pancreatic).
c-Mass; Crohn's disease, lymphoma, tuberculosis.
2-Extraintestinal features
1-Skin;
a-Nonspecific; Pigmentation, thinning, reduced subcutaneous fat.
b-Specific; Blisters (dermatitis herpetiformis), erythema nodosum (Crohn's disease), petechiae and purpura (vitamin K and C deficiency), edema (hypoproteinemia), acrodermatitis enteropathica (zinc deficiency), follicular hyperkeratosis (vitamin A deficiency).
2-Hair; Alopecia or thinning; hypothyroidism, gluten sensitivity
3-Eyes;
a-Conjunctivitis, episcleritis; Crohn's disease, Behçet's syndromeb-Paleness; Severe anemia.
c- Night blindness or Bitot’s spot; vit. A deficiency.
4-Mouth;
a- Aphthous ulcers; Crohn's disease, gluten sensitivity, Behçet's syndrome
b-Glossitis; Defici. of vit. B12, iron, folate and niacin
c-Angular cheilosis; Deficie of vit. B12, iron, folate, B complex
d-Gum bleeding; vit. C deficiency.
4-Hands;
a-Raynaud's phenomenon; Sclerodermab-Finger clubbing; Crohn's disease, lymphoma
c-Koilonychia; Iron deficiency
d-Leukonychia; hypoproteinemia
5-Musculoskeletal;
a-Mono/polyarthropathy; Crohn's disease, gluten sensitivity, Whipple's disease, Behçet's syndrome
b-Back pain (osteomalacia/osteoporosis/sacroiliitis); Crohn's disease, gluten sensitivity, vit. D deficiency.
c-Muscle weakness; (low K, magnesium, vitamin D)
6-Nervous system ;
a-Peripheral neuropathy; (weakness, paresthesias, numbness) ;Vitamin B12 deficiency
b-Cerebral; (seizures, dementia, intracerebral calcification, meningitis, pseudotumor, cranial nerve palsies) ;Whipple's disease, gluten sensitivity, diffuse lymphoma.
Investigation of malabsorption
Routine blood tests of malabsorption:a-Haematology;
Microcytic anaemia (iron deficiency)
Macrocytic anaemia (folate or B12 deficiency)
Increased prothrombin time (vitamin K deficiency)
b-Biochemistry;
Hypoalbuminaemia
Hypocalcaemia
Hypomagnesaemia
Deficiencies of phosphate and zinc
c-Serology; IgA antiendomysial Ab +ve in celiac dis.
Investigations of bile salt malabsorption (SeHCAT test);
SeHCAT is radiolabeled bile salt in capsule. It’s serum level of less than 15% after ingestion of capsule is abnormal.
Schilling test (vitamin B12 malabsorption);
using a radiolabeled vitamin B12 as a marker.
malabsorption of vitamin B12 can occur because of lack of intrinsic factor (e.g., pernicious anemia or gastric resection), pancreatic insufficiency, bacterial overgrowth, or ileal disease.
COELIAC DISEASE
Coeliac disease; is an immunologically mediated inflammatory disorder of the small bowel occurring in genetically susceptible individuals and resulting from intolerance to wheat gluten and similar proteins found in rye, barley and, to a lesser extent, oats.Gluten = Glutenin + Gliadin.
Tissue transglutaminase (TTG) is the autoantigen for anti-endomysial antibodies, used in serological diagnosis.
Wheat
Barley
Rye
Oats
After being taken up by epithelial cells, gluten peptides are deamidated by the enzyme tissue transglutaminase in the subepithelial layer. They are then able to fit the antigen-binding motif on HLA-DQ2 positive antigen presenting cells. Recognition by CD4+ T cells triggers a Th1 immune response with generation of pro-inflammatory cytokines (IL-1, IFN-γ and TNF-α). Lymphocytes infiltrate the lamina propria, and increased intraepithelial lymphocytes (IEL), crypt hyperplasia and villous atrophy ensue.
Clinical features;
Typical features; presents with steatorrhea, with abdominal distension, weight loss, and delayed growth.
Atypical features; tiredness, folate or IDA or oral ulcers.
Extraintestinal features; depression, arthralgias, osteoporosis, or osteomalacia.
Associations; dermatitis herpetiformis, type 1 diabetes mellitus, autoimmune thyroid disease.
Bulky, oily, pale and offensive stools which float in the toilet (steatorrhoea) signify fat malabsorption.
Investigations;
1- Duodenal or jejunal biopsy; an increase in mucosal lymphocytes and plasma cells (the infiltrative lesion) with partial blunting or total villous flattening.2-Antibodies; Serum antigliadin (especially IgA) and Anti-endomysial antibodies IgA Ab.
3-Haematology and biochemistry; Microcytic or macrocytic anaemia from iron or folate deficiency , reduced concentrations of calcium, magnesium, total protein, albumin or vitamin D.
4-Barium follow-through; dilated loops of bowel, diminished folds , flocculation of contrast.
Important causes of subtotal villous atrophy
Coeliac diseaseTropical sprue
Dermatitis herpetiformis
Lymphoma
AIDS enteropathy
Giardiasis
Hypogammaglobulinaemia
Radiation
Whipple's disease
Zollinger-Ellison syndrome
Management;
1-Correct existing deficiencies of iron, folate, calcium and/or vitamin D.2-Commence a life-long gluten-free diet.
Exclusion of wheat, rye, barley and initially oats
Introduced rice, maize and potatoes as a sources of carbohydrates.
Booklets produced by coeliac societies.
Follow up;
1-Regular monitoring; of symptoms, weight and nutrition is essential.2-Compliance to diet.
3-Good response; improve symptoms with disappearance of anti-endomysial antibodies.
4-Repeat jejunal biopsies; If symptoms do not improved or antibodies remain persistently positive.
Complications of celiac disease;
1- Intestinal lymphoma
2- Small bowel carcinoma
3- Squamous carcinoma of the oesophagus
4- Ulcerative jejunoileitis
DERMATITIS HERPETIFORMIS;
It is skin lesion characterised by crops of intensely itchy blisters over the elbows, knees, back and buttocks , due to IgA Ab deposition, associated with partial villous atrophy on jejunal biopsy, responds to a gluten-free diet, some time with addition of dapsone.TROPICAL SPRUE;
Chronic, progressive malabsorption in a patient in or from the tropic, associated with small intestinal infection. Tetracycline 250 mg 6-hourly for 28 days is the treatment of choice, with folic acid supplementation lead to improve symptoms and jejunal morphology.
SMALL BOWEL BACTERIAL OVERGROWTH ('BLIND LOOP SYNDROME')
The count of coliform organisms in small intestine may be 108-1010/ml organisms considered bacterial overgrowth. The normal contain less than 104/ml organisms in the duodenum and jejunum.Due to impair the normal physiological mechanisms controlling bacterial proliferation in the intestine.
Patient presents with watery diarrhoea and/or steatorrhoea, with anaemia due to B12 deficiency.
Treatment of the underlying cause. Tetracycline is the treatment of choice. Metronidazole or ciprofloxacin is an alternative. Intramuscular vitamin B12 supplementation may be needed in chronic cases.
ILEAL RESECTION;
Malabsorption that results from ileal resection, for example following surgery for Crohn's disease, that leads to Vitamin B12 and bile salt malabsorption.Unabsorbed bile salts pass into the colon stimulating water and electrolyte secretion and causing watery diarrhoea.
Other consequences of ileal resection shown in the next slide
Diarrhoea usually responds to colestyramine. Aluminium hydroxide is an alternative. Parenteral vitamin B12 supplementation is necessary.
Consequences of ileal resection.
Megaloblastic anemia due to vitamin B12 deficiency. A- the tongue is smooth, shiny and loss of papillae. B- blood film: macrocytosis, hypochromia and hypersegmented neutrophil.
A
B
Quiz
Clinical case:A 35 year old female with Crohn’s disease since the age of 15 years, present with history of foul smelling diarrhea and weigh loss. Investigations are showing;
Hb 10 g/dl, WBC 7 x 109/l , Platelets 199 x 109/l
MCV 106 fl, Serum folate 23 µg/l (NR 20 µg/l ), Serum B12 65 ng/l (NR 600 ng/l ),
Fecal fat excretion 50 mmol/l (NR < 20 mmol/l)
Schilling test; Pre-intrinsic factor 2% B12 isotope excreted. Post-intrinsic factor 2% B12 isotope excreted.
List tow possible causes for this patient symptoms?
What investigation would you performed next?
Thanks